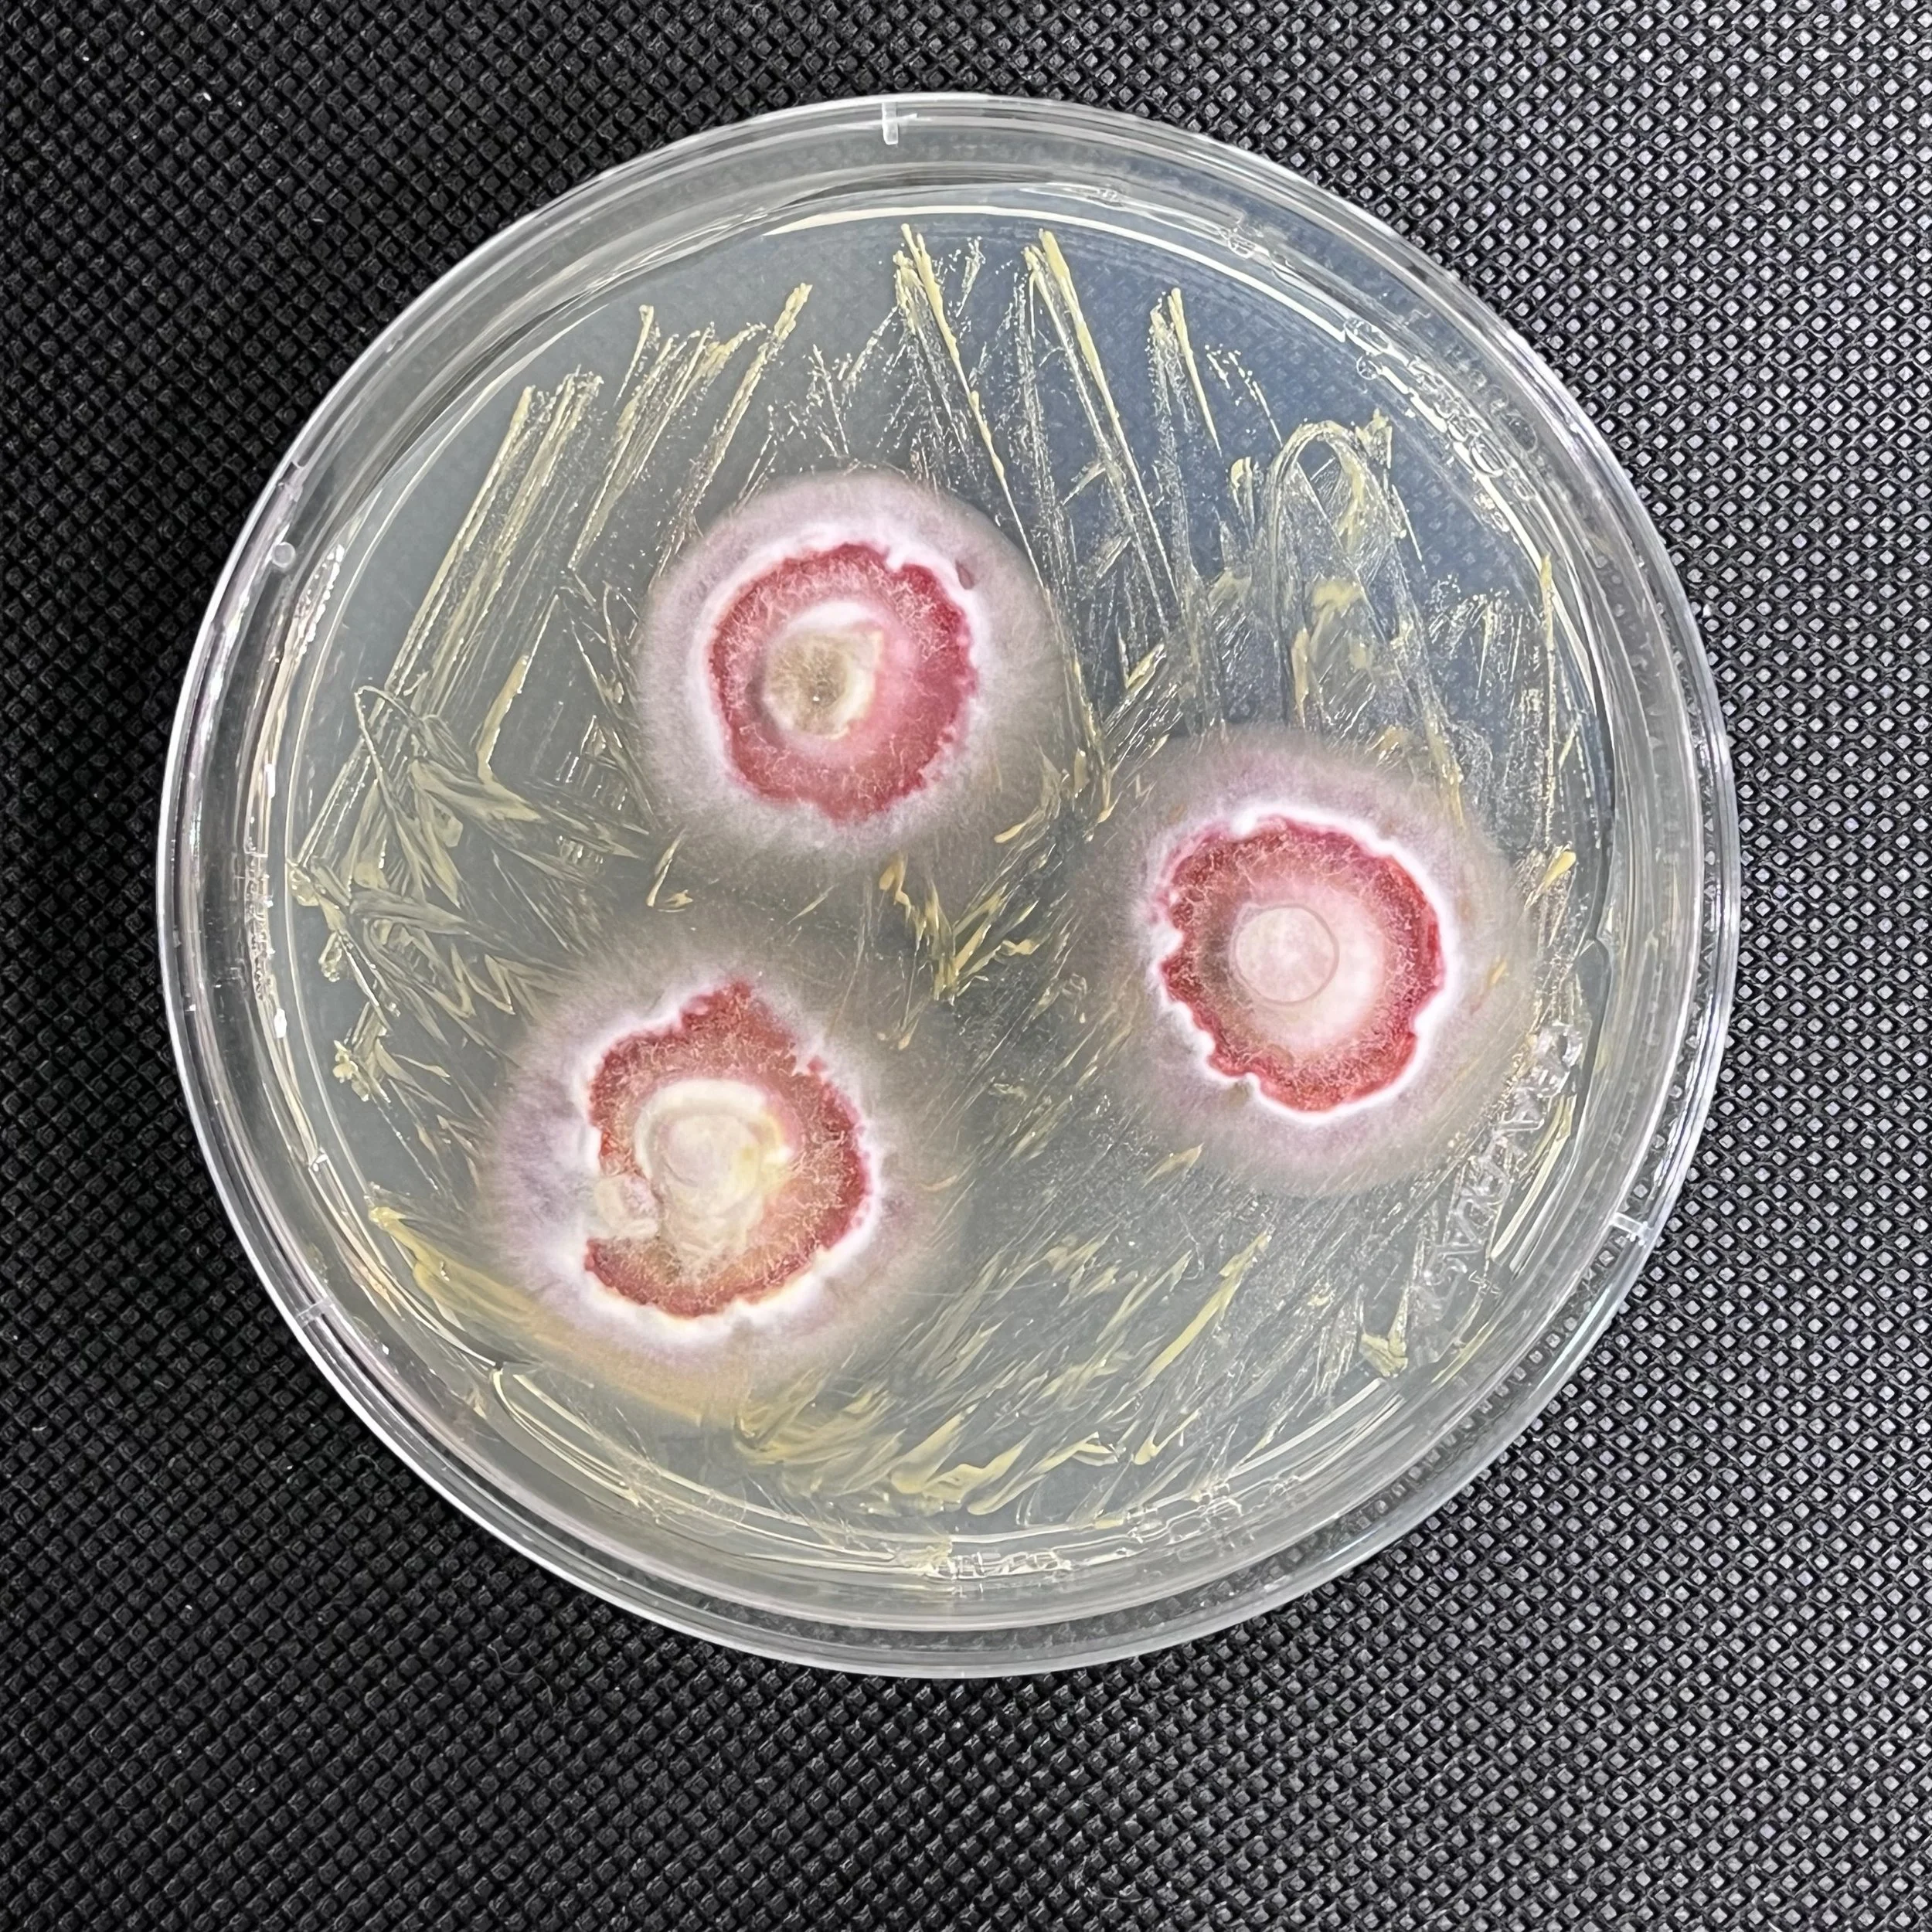

I’m Gustavo Santos!
My name is Gustavo Santos, and I am a pharmacist with a PhD in Science from the School of Pharmaceutical Sciences of Ribeirão Preto, University of São Paulo. I was born on a small island in the middle of the Amazon rainforest in Brazil, in a town called Parintins. Parintins is surrounded by the Amazon River and deeply immersed in indigenous culture. I completed my undergraduate degree in Pharmacy in Manaus, the capital of Amazonas state, Brazil, and spent a year at Saint John’s University in New York City.
The path may be filled with challenges, but persistence and determination will help you overcome obstacles.
At Saint John’s University, I made my first contact with a scientific career during an internship at Professor Ashley Martino’s laboratory, focusing on viral gene therapy. When I returned to Brazil, I began a Scientific Initiation program at the National Institute for Amazonian Research (INPA). My research there involved isolating compounds from Amazonian plants to test their ability to inhibit the growth of Plasmodium falciparum, the causative agent of Malaria, a neglected tropical disease that primarily affects poor and isolated communities in the Amazon.
After graduation, I moved to Ribeirão Preto to start my PhD. I was captivated by the idea of researching marine organisms and was excited to study those from the Antarctic continent. In 2017, I traveled to Antarctica to collect samples of the endemic seaweed, Phaeurus antarcticus, with the logistic support of the Brazilian Antarctic Program (PROANTAR). We visited various islands across the Antarctic Peninsula to collect seaweed samples.
I was born on a small island in the middle of the Amazon rainforest in Brazil, in a town called Parintins. Parintins is surrounded by the Amazon River and deeply immersed in indigenous culture.
My research involved studying the chemical profile of the seaweed, describing the types of chemical compounds it produced, and examining how these compounds varied according to the collection location. Additionally, I investigated the fungal community associated with the seaweed, aiming to describe the fungi living within the seaweed and explore the biotechnological potential of the compounds they produced. I focused on searching for new antiparasitic, photoprotective, and antibacterial compounds. My PhD thesis is titled “Phaeurus antarcticus and its endophytic fungi: Chemical diversity of a hidden pharmacy beneath the Antarctic Ocean.”
Scientific research is a constantly evolving field, and a genuine interest in discovery will sustain you through difficult times.
My research has always been closely tied to my belief in the necessity of building a better future. By using biodiversity to fight neglected tropical diseases, finding new alternatives for traditional sunscreens (which may harm marine life), and contributing to the discovery of new antimicrobial compounds, I aim to demonstrate that nature provides all we need. “Hey we have everything we need from nature, lets perverse it, describe it, and use responsibly the resources we have”. I was born in the Amazon region, which is affected by climate change. I am currently working with seaweeds from the Brazilian Coast and we know that ocean warming and acidification is putting marine life at risk. Additionally, the Antarctic Peninsula is one of the most rapid warming places in the world, so it is necessary to unveil its biodiversity. That’s what I believe as a scientist and citizen.
Understanding how nature works fascinates me, and I use this passion to inspire the next generation of polar explorers. I am currently supervising two undergraduate students, Maria Paula Machado Cardoso and Nandjane Boa Morte, on projects that use co-culture experiments (mixing two different organisms to mimic their interaction in nature) to obtain new compounds with antibacterial and antifungal potential. We are working with various Antarctic fungi isolated from the seaweed Phaeurus antarcticus.
This highlights the biotechnological potential of Antarctic fungi. Their chemistry and ability to produce compounds that ensure their survival in the harsh Antarctic environment may represent a “cure in the ice.”
I love spending time outdoors, especially walking on the beach and sunbathing with friends. These activities allow me to unwind and appreciate nature, which is a significant part of my life. I have a strong connection to my hometown of Parintins, where one of the largest indigenous festivals in the world takes place—the Parintins Festival.
It's not every day that a boy from the Amazon travels halfway around the world to participate in an Antarctic expedition.
This festival, held annually in Parintins in the state of Amazonas, is based on the tradition of boi-bumbá. It features music, rituals, and the iconic "auto do boi." The festival revolves around the rivalry between two boi-bumbás, Boi Caprichoso and Boi Garantido. Over three days, these teams tell indigenous legends and tales, emphasizing the importance of nature preservation and drawing attention to the political issues faced by indigenous populations in modern society.
The Parintins Festival is marked by the intense competition between the passionate red supporters of Boi Garantido and the blue supporters of Boi Caprichoso. I proudly support Team Blue, Caprichoso. The festival is so influential that even major companies like Coca-Cola produce blue cans for the event, despite their original red color.
This festival and my cultural heritage deeply influence my work and my commitment to preserving nature and promoting biodiversity. They inspire me to advocate for environmental conservation and indigenous rights in both my personal and professional life.
I am currently moving back to the state of São Paulo to start a new research project at the Institute of Chemistry – UNESP. This project will evaluate how Antarctic fungi respond to changing abiotic factors related to climate change and the types of metabolites they produce under these stress conditions. My goal is to determine if these metabolites pose any danger to humans, animals, and crops.
As a young scientist, I feel a duty to change the way people perceive the polar regions and demonstrate that they are more connected to our daily lives than we realize. This connection drives my research and advocacy efforts.
This experience was transformative both scientifically and personally.
Over the past two years, I have also been involved in APECS Brasil (Association of Polar Early Career Scientists). This organization has provided me with valuable opportunities to collaborate with fellow early-career scientists, share research, and advocate for polar science.
In addition to my scientific work, I am actively involved in the Rato de Bibliotecas Project. This initiative raises funds to build libraries in isolated communities across the Amazonas and Pará states. We currently have two libraries serving children in these local communities. Please take a look at our work on Instagram and share it!
Through both my research and community engagement, I aim to make a meaningful impact on both environmental preservation and education in underserved areas.
My research has always been closely tied to my belief in the necessity of building a better future.
I consider myself very fortunate to have had the opportunity to travel to Antarctica at the beginning of my PhD. This experience was transformative both scientifically and personally. Witnessing the white and dangerous magnificence of Antarctica first hand was life-changing. The vast, pristine landscapes and the unique challenges of conducting research in such an extreme environment left an indelible mark on me. It deepened my appreciation for the fragility and importance of these remote regions and solidified my commitment to studying and preserving them. This journey ignited a passion for polar exploration that continues to drive my work today.
My family is incredibly proud of my achievements, particularly my involvement in polar research. My journey has sparked their curiosity about the polar regions, especially Antarctica. It's not every day that a boy from the Amazon travels halfway around the world to participate in an Antarctic expedition. This uncommon path has not only broadened their understanding of these remote areas but also filled them with a sense of pride and wonder. Their support and interest motivate me to continue my work.
I consider myself very fortunate to have had the opportunity to travel to Antarctica at the beginning of my PhD.
I hope to settle in a research institute or university soon and start my own laboratory. After completing my PhD, I have been working as a postdoc, but securing funding is challenging without tenure. Given the importance of my research area to Brazil's scientific development, I remain optimistic that this will change soon. In the future, I would also like to expand my research to include Arctic organisms, exploring their unique adaptations and potential biotechnological applications. Establishing my own lab would allow me to delve deeper into these studies and contribute significantly to our understanding of both polar regions.
What inspires me most is the deep connection we can create with nature. The intricate relationships between living organisms and their environments are endlessly fascinating and motivating. This connection drives my passion for research and conservation. My advice is: be resilient and curious. Resilience: Especially if you are from a developing country, resilience is key. The path may be filled with challenges, but persistence and determination will help you overcome obstacles. Curiosity: Stay curious and open to learning. Scientific research is a constantly evolving field, and a genuine interest in discovery will sustain you through difficult times.
Follow Gustavo on Instagram / X @gustsantoos for more about his work!